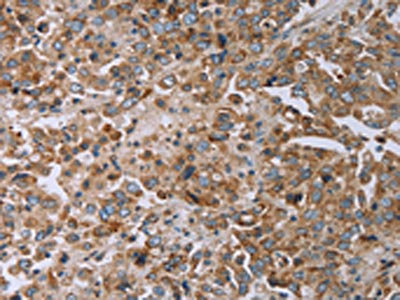

TNPO1 Antibody
-
中文名稱:TNPO1兔多克隆抗體
-
貨號:CSB-PA042633
-
規(guī)格:¥1100
-
圖片:
-
其他:
產(chǎn)品詳情
-
Uniprot No.:
-
基因名:TNPO1
-
別名:Importin 2 antibody; Importin beta 2 antibody; Importin beta-2 antibody; IPO 2 antibody; IPO2 antibody; Karyopherin (importin) beta 2 antibody; Karyopherin beta 2 antibody; Karyopherin beta-2 antibody; KPN B2 antibody; KPNB 2 antibody; KPNB2 antibody; M9 interacting protein antibody; M9 region interacting protein antibody; M9 region interaction protein antibody; MIP 1 antibody; MIP antibody; MIP1 antibody; OTTHUMP00000126960 antibody; OTTHUMP00000222024 antibody; OTTHUMP00000226224 antibody; TNPO 1 antibody; Tnpo1 antibody; TNPO1_HUMAN antibody; Transportin 1 antibody; Transportin antibody; Transportin-1 antibody; Transportin1 antibody; TRN antibody
-
宿主:Rabbit
-
反應(yīng)種屬:Human,Mouse
-
免疫原:Synthetic peptide of Human TNPO1
-
免疫原種屬:Homo sapiens (Human)
-
標(biāo)記方式:Non-conjugated
-
抗體亞型:IgG
-
純化方式:Antigen affinity purification
-
濃度:It differs from different batches. Please contact us to confirm it.
-
保存緩沖液:-20°C, pH7.4 PBS, 0.05% NaN3, 40% Glycerol
-
產(chǎn)品提供形式:Liquid
-
應(yīng)用范圍:ELISA,IHC
-
推薦稀釋比:
Application Recommended Dilution ELISA 1:1000-1:2000 IHC 1:25-1:100 -
Protocols:
-
儲存條件:Upon receipt, store at -20°C or -80°C. Avoid repeated freeze.
-
貨期:Basically, we can dispatch the products out in 1-3 working days after receiving your orders. Delivery time maybe differs from different purchasing way or location, please kindly consult your local distributors for specific delivery time.
-
用途:For Research Use Only. Not for use in diagnostic or therapeutic procedures.
相關(guān)產(chǎn)品
靶點(diǎn)詳情
-
功能:Functions in nuclear protein import as nuclear transport receptor. Serves as receptor for nuclear localization signals (NLS) in cargo substrates. Is thought to mediate docking of the importin/substrate complex to the nuclear pore complex (NPC) through binding to nucleoporin and the complex is subsequently translocated through the pore by an energy requiring, Ran-dependent mechanism. At the nucleoplasmic side of the NPC, Ran binds to the importin, the importin/substrate complex dissociates and importin is re-exported from the nucleus to the cytoplasm where GTP hydrolysis releases Ran. The directionality of nuclear import is thought to be conferred by an asymmetric distribution of the GTP- and GDP-bound forms of Ran between the cytoplasm and nucleus. Involved in nuclear import of M9-containing proteins. In vitro, binds directly to the M9 region of the heterogeneous nuclear ribonucleoproteins (hnRNP), A1 and A2 and mediates their nuclear import. Appears also to be involved in hnRNP A1/A2 nuclear export. Mediates the nuclear import of ribosomal proteins RPL23A, RPS7 and RPL5. Binds to a beta-like import receptor binding (BIB) domain of RPL23A. In vitro, mediates nuclear import of H2A, H2B, H3 and H4 histones, and SRP19. Mediates nuclear import of ADAR/ADAR1 isoform 1 and isoform 5 in a RanGTP-dependent manner.; (Microbial infection) In case of HIV-1 infection, binds and mediates the nuclear import of HIV-1 Rev.
-
基因功能參考文獻(xiàn):
- TNPO1-mediated nuclear import may constitute a novel input pathway of how cellular redox state signals to the clock, since redox stress increases binding of TNPO1 to PER1 and decreases its nuclear localization. TNPO1 is one of the novel players essential for normal circadian periods and potentially for redox regulation of the clock. PMID: 29377895
- A molecular docking and dynamics study concluded that R521C and R521H mutations in FUS result in weak binding with Karyopherin-beta2 leading to amyotrophic lateral sclerosis. PMID: 27381509
- Data suggest that micoRNA-128 targets the 3prime-untranslated region of nuclear import factor transportin 1 (TNPO1) mRNA. PMID: 28974576
- the TNPO1-Rab8-ciliary targeting signals complex mediates selective entry into and retention of cargos within cilia. PMID: 27633000
- Together, these results indicate that transportin-1 mediates YB-1 nuclear translocation. PMID: 27794479
- findings suggest that a new player, i.e., O-GlcNAcylation, regulates hnRNP A1 translocation and interaction with Trn1, possibly affecting its function PMID: 27913144
- Results show that Karyopherin-b2 binds to the N-terminal tail of histone H3 with high affinity even though H3 lacks a recognizable proline-tyrosine nuclear localization signal (PY-NLS). PMID: 27618664
- FGF2 nuclear translocation is regulated by Karyopherin-beta2 and Ran GTPase in human glioblastoma cells PMID: 26056081
- Kapbeta2 interacts with ULK2 through ULK2's putative PY-NLS motif, and facilitates transport from the cytoplasm to the nucleus, depending on its Ser1027 residue phosphorylation by PKA, thereby reducing autophagic activity. PMID: 26052940
- Studies indicate potential roles of Tranportin-1 and Transportin-2 beyond protein nuclear import. PMID: 24780099
- ADAR1 carries a unique nuclear localization signal (NLS) that overlaps one of its double-stranded RNA-binding domains (dsRBDs). This dsRBD-NLS is recognized by nuclear import receptor transportin 1 (also called karyopherin-beta2) in an RNA-sensitive manner. PMID: 24753571
- Data suggest the C-terminal nuclear localization domain (QYP) is critical for RAM (RNMT-activating mini protein) to enter the cell nucleus where RAM activates RNMT resulting in mRNA cap methylation; TNPO1/TNPO2 mediate RAM nuclear entry. PMID: 24200467
- C-terminal FUS mutations prevent TNPO 1 binding to the NLS, inhibiting nuclear import and promoting cytoplasmic aggregation. The presence of TNPO 1 in wild-type FUS aggregates in frontotemporal lobar degeneration-FUS distinguishes it from ALS. PMID: 22934812
- Crystal structure of human Karyopherin beta2 bound to the PY-NLS of Saccharomyces cerevisiae Nab2 PMID: 23535894
- The crystal structure of the FUS-NLS/Trn1 complex shows extensive contacts between the two proteins and a unique alpha-helical structure in the FUS-NLS. PMID: 23056579
- Disulfide formation with transportin-1 is required for nuclear localization and the activation of FOXO4 induced by reactive oxygen species. PMID: 23333309
- In case of L7, importin beta2 or importin beta3 are preferentially used by clusters with a high import efficiency. PMID: 23266416
- These data imply a specific dysfunction in the interaction between Trn1 and FET proteins in the inclusion body formation in FTLD-FUS. PMID: 22842875
- arginine methylation impairs TRN dependent nuclear import of FUS, by decreasing binding of TRN to a novel TRN-binding motif next to the proline-tyrosine nuclear localization signal of FUS. PMID: 22968170
- Transportin binding might delay methylation of PABPN1 until after nuclear import. PMID: 21808065
- Data demonstrate that Importin beta2 is necessary for localization of retinitis pigmentosa 2 (RP2) to the primary cilium, and identify two distinct binding sites of RP2, which interact independently with Importin beta2. PMID: 21285245
- Nuclear import of fused in sarcoma (FUS) is dependent on Transportin, and interference with this transport pathway leads to cytoplasmic redistribution and recruitment of fused in sarcoma (FUS) into stress granules. PMID: 20606625
- Results suggest that hnRNP H and F are nuclear shuttling proteins whose posttranslational modifications may alter interaction with transportin 1, nuclear localization, and hence function. PMID: 20308327
- nuclear import of the HPV16 E6 oncoprotein in digitonin-permeabilized HeLa cells could be mediated by Kap beta2 PMID: 12551970
- 1 major capsid protein of human papillomavirus type 11 interacts with Kap beta2 nuclear import receptor PMID: 12620808
- HPV16 L2 interacts via its NLSs with a network of karyopherins and can enter the nucleus via several import pathways mediated by Kapalpha(2)beta(1) heterodimers, Kapbeta(2), and Kapbeta(3). PMID: 15507604
- Results describe four crystal structures of human transoprtin 1 in a substrate-free form as well as in the complex with three nuclear localization signals. PMID: 17936704
- the 3.0 A crystal structure of unliganded Kap beta2, which consists of a superhelix of 20 HEAT repeats PMID: 17997969
- TRN1-binding to CCR2 promotes its nuclear translocation in a TRN1-dependent manner. PMID: 18846510
- we identify transportin-1 as the import receptor for ADAR1. PMID: 19124606
- Ran in complex with importin-beta has a higher affinity for GTP. This feature is responsible for the generation of Ran-GTP from Ran-GDP by importin-beta. PMID: 19549784
- The interplay of the two negative regulators, transportin and importin beta, along with the positive regulator RanGTP, allows precise choreography of multiple cell cycle assembly events. PMID: 19641022
顯示更多
收起更多
-
亞細(xì)胞定位:Cytoplasm. Nucleus.
-
蛋白家族:Importin beta family, Importin beta-2 subfamily
-
數(shù)據(jù)庫鏈接:
Most popular with customers
-
-
YWHAB Recombinant Monoclonal Antibody
Applications: ELISA, WB, IHC, IF, FC
Species Reactivity: Human, Mouse, Rat
-
Phospho-YAP1 (S127) Recombinant Monoclonal Antibody
Applications: ELISA, WB, IHC
Species Reactivity: Human
-
-
-
-
-